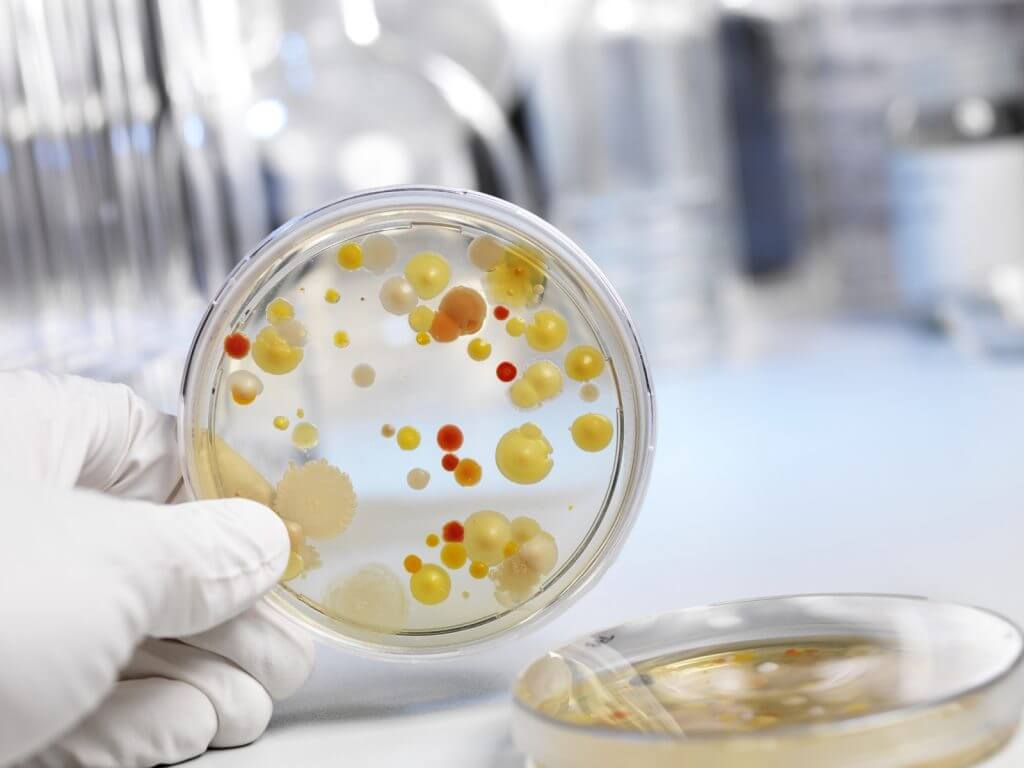
image

Содержание
За свою жизнь организм человека сталкивается с огромным количеством инфекций и, проходя курсы лечения, неизбежно получает бланки с направлениями на всевозможные виды анализов. В этой статье мы рассмотрим довольно распространенный вид анализа — бакпосев мочи и разберемся, как правильно сдавать материал для исследования.
Что такое бакпосев на флору
Бактериологический посев — высокоточное лабораторное микробиологическое исследование урины, позволяющее определить вид и количественное содержание патогенных бактерий (бактериурия) в исследуемом материале, а также чувствительность к основным группам антибиотиков.
Несмотря на сложности, связанные со сбором и микроскопией материала, правильно проведенное исследование обеспечивает рациональное назначение антибиотикотерапии для лечения очага бактериальной инфекции.
Показания к бактериологическому исследованию
Важнейшей целью проведения анализа является выявление возбудителя инфекций в мочеполовых путях, как у мужчин, так и у женщин.
Лечащий врач может назначить бакпосев на микрофлору и чувствительность к антибиотикам, руководствуясь следующими показаниями:
- подозрение на развитие пиелонефрита у пациента;
- инфекции мочевых путей у мужчин и женщин;
- подозрение на урологическую инфекцию у беременных;
- осложненные инфекции мочевыводящих путей у пациентов старше 65 лет;
- наличие рецидивирующих урологических инфекций;
- подозрение на инфекции, связанные с проведением медицинских манипуляций (катетеризация, цистоскопия и т. д.);
- подтверждение сахарного диабета или туберкулеза;
- если ранее проводимая антибиотикотерапия малоэффективна или неэффективна.

Виды посевов мочи
Условно посевы урины можно разделить на два вида:
- На тип микрофлоры . Подразумевается, что кроме обнаружения бактериурии, определяется наличие патогенных простейших и грибков (например, Trichomonas vaginalis, хламидии, грибки рода Candida). Лаборант выделяет осадок мочи и производит микроскопию материала. В случае выявления патогенной флоры, культуру бактерий выделяют путем посева мазка на питательную среду. Как только колония микроорганизмов достигает количества, достаточного для исследования, лаборант делает выводы о виде бактериальной флоры.
- На чувствительность к антибиотикам. Этот вид исследования имеет важное значение при установлении метода лечения и корректировке антибиотикотерапии. Суть метода — посев материала в специальную лабораторную посуду, разделенную на несколько секторов с определенным видом антибиотика. Лаборант наблюдает за развитием колоний: в секторе, где не наблюдается рост бактерий, находится антибиотик, подходящий для лечения пациента, в тех секторах, где, напротив, обнаруживается бурный рост — они резистентны, т. е. нечувствительны к лекарству.
Как правильно собрать мочу на посев
Простые правила сбора урины, позволяющие избежать неверных результатов микроскопии:
- Емкость для хранения и транспортировки материала должна быть стерильна . Оптимально использование специального пластикового контейнера, продающегося в любой аптеке.
- Не рекомендуется мочиться в течение двух часов до сбора материала.
- Запрещен сбор материала в период менструации у женщин, антибиотикотерапии, лечения вагинальными свечами и спринцеваниями.
- Перед мочеиспусканием должна быть проведена тщательная гигиена наружных половых органов, но без использования мыла и других моющих средств.
- Первая порция урины спускается в унитаз, последующая собирается непосредственно в транспортировочную емкость. Достаточно средней порции для исследования.
- После сбора контейнер с собранной уриной плотно закрывается крышкой и сдается в лабораторию в течение часа.

Расшифровка результатов
Теперь узнаем, что показывает анализ мочи на посев. При получении результата, на бланке вам встретится аббревиатура КОЕ. КОЕ или колониеобразующая единица — один живой микроорганизм или их группа, образующая видимые глазу колонии.
Расшифровка:
- если выявлено менее 1000 КОЕ/мл, то имеет место занесение культуры с наружных половых органов, лечение в этом случае не требуется;
- от 1000 до 10000 КОЕ/мл — промежуточный результат, скорее всего лечащий врач направит на пересдачу анализа;
- более 100000 КОЕ/мл — имеет смысл говорить о воспалении, связанном с этим возбудителем, требуется антибиотикотерапия.
При положительном анализе приводятся обнаруженные микроорганизмы , а также (если проводилась антибиотикограмма) результаты чувствительности к определенной группе лекарств. На основании расшифровки результатов врач назначает или корректирует дальнейшее лечение.
Бакпосев мочи при беременности
Отдельно стоит отметить, что при беременности в обязательном порядке назначается бакпосев при постановке на учет в женской консультации и в 36 недель беременности. По результатам общего анализа мочи (ОАМ) и крови (ОАК) или биохимического анализа крови, исследование может назначаться чаще. Даже в случае отсутствия жалоб, посев на микрофлору позволяет выявить бессимптомную бактериурию и вылечить опасные патологии матери и плода.
Видео
Как правильно сдавать баканализ мочи на посев можно посмотреть в видеоматериале.
Частые вопросы
Как правильно сдавать мочу на бакпосев?
Для сдачи мочи на бакпосев необходимо соблюдать правила гигиены, собрать утреннюю порцию мочи в специальный контейнер и доставить его в лабораторию в течение 1-2 часов.
Зачем проводится бакпосев мочи?
Бакпосев мочи проводится для выявления микроорганизмов, вызывающих инфекции мочевыводящих путей, и определения их чувствительности к антибиотикам.
Полезные советы
СОВЕТ №1
Перед сдачей мочи на бакпосев следует тщательно помыть наружные половые органы с мылом и водой, чтобы избежать попадания лишней микрофлоры в анализ.
СОВЕТ №2
Необходимо собирать утреннюю порцию мочи в специальный стерильный контейнер, предварительно промыв его чистой водой и обезжирив его.
СОВЕТ №3
Важно сдать анализ в лабораторию как можно быстрее после сбора мочи, чтобы избежать роста бактерий в пробирке и получить достоверные результаты.









